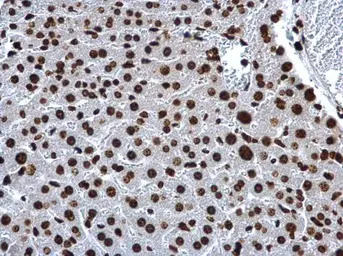
产品细节图片2

相关产品推荐更多 >
万千商家帮你免费找货
0 人在求购买到急需产品
- 详细信息
- 文献和实验
- 技术资料
- 免疫原:
Full length human Histone H2A Recombinant protein.
- 亚型:
IgG
- 形态:
Liquid
- 保存条件:
Store as concentrated solution. Centrifuge briefly prior to opening vial. For short-term storage (1-2 weeks), store at 4ºC. For long-term storage, aliquot and store at -20ºC or below. Avoid multiple freeze-thaw cycles.
- 克隆性:
Polyclonal
- 标记物:
Unconjugated
- 适应物种:
Human, Mouse, Rat
- 保质期:
12 months from the shipping date of the product.
- 抗原来源:
Human
- 目录编号:
GTX129418
- 级别:
Primary Antibodies
- 库存:
Available
- 供应商:
GeneTex
- 宿主:
Rabbit
- 应用范围:
WB, ICC/IF, IHC-P
- 浓度:
1 mg/ml (Please refer to the vial label for the specific concentration.)
- 靶点:
Histone H2A
- 抗体英文名:
Histone H2A antibody
- 抗体名:
Histone H2A 抗体
- 规格:
100 μl/25 μl
| 规格: | 100 μl | 产品价格: | ¥4000.0 |
|---|---|---|---|
| 规格: | 25 μl | 产品价格: | ¥1700.0 |

Histone H2A antibody detects Histone H2A protein at nucleus on mouse kidney by immunohistochemical analysis.
Sample: Paraffin-embedded mouse kidney.
Histone H2A antibody (GTX129418) dilution: 1:500.
Antigen Retrieval: Trilogy™ (EDTA based, pH 8.0) buffer, 15min
Histone H2A antibody detects Histone H2A protein at nucleus on mouse kidney by immunohistochemical analysis.
Sample: Paraffin-embedded mouse kidney.
Histone H2A antibody (GTX129418) dilution: 1:500.
Antigen Retrieval: Trilogy™ (EDTA based, pH 8.0) buffer, 15min

Histone H2A antibody detects Histone H2A protein at nucleus on mouse intestine by immunohistochemical analysis.
Sample: Paraffin-embedded mouse intestine.
Histone H2A antibody (GTX129418) dilution: 1:500.
Antigen Retrieval: Trilogy™ (EDTA based, pH 8.0) buffer, 15min

Histone H2A antibody detects Histone H2A protein at nucleus on rat fore brain by immunohistochemical analysis.
Sample: Paraffin-embedded rat fore brain.
Histone H2A antibody (GTX129418) dilution: 1:500.
Antigen Retrieval: Trilogy™ (EDTA based, pH 8.0) buffer, 15min

Various whole cell extracts (30 μg) were separated by 15% SDS-PAGE, and the membrane was blotted with Histone H2A antibody (GTX129418) diluted at 1:10000. The HRP-conjugated anti-rabbit IgG antibody (GTX213110-01) was used to detect the primary antibody.
风险提示:丁香通仅作为第三方平台,为商家信息发布提供平台空间。用户咨询产品时请注意保护个人信息及财产安全,合理判断,谨慎选购商品,商家和用户对交易行为负责。对于医疗器械类产品,请先查证核实企业经营资质和医疗器械产品注册证情况。
 文献和实验
文献和实验Romero A et al., Dev Comp Immunol 2019 (PMID:31877326)
Huang FI et al., Front Oncol 2019 (PMID:31024851)
Bronstein R et al., Front Mol Neurosci 2017 (PMID:28588451)
Alison A Chomiak et al., iScience 2022 (PMID:35601919)
Yan Guo et al., iScience 2022 (PMID:35754718)
Ho CH et al., Front Physiol 2021 (PMID:34925053)
Wang Y et al., Cell Death Dis. 2021 (PMID:33608512)
Histone Acetylation and Deacetylation
transcription (1 ,2 ). DNA is packaged into chromatin, a highly organized and dynamic protein-DNA complex. The fundamental subunit of chromatin, the nucleosome, is composed of an octomer of four core histones, an H3/H4 tetramer and two H2A/H2B dimers, surrounded
组蛋白是和染色体相联的最主要的蛋白质。它的作用是和染色体中的 DNA 的负电荷结合。组蛋白是比较小的碱性蛋白;在细胞正常 pH 值时,组蛋白带有正电荷,这样它们就可以和 DNA 结合,这个正电荷主要存在于碱性氨基酸 Lys 和 Arg 的 -NH3 上。其实,组蛋白约含 25% 的 Arg 和 Lys 。比其他蛋白的 Arg , Lys 的含量都多。和真核 DNA 结合的有 5 种类型的组蛋白: H1 , H2A , H2B , H3
组蛋白是真核生物染色体的基本结构蛋白, 是一类小分子碱性蛋白质, 有五种类型:H1 、H2A 、H2B 、H3 、H4,它们富含带正电荷的碱性氨基酸, 能够同DNA中带负电荷的磷酸基团相互作用。 组蛋白的基因非常保守。亲缘关系较远的种属中, 四种组蛋白(H2A、H2A、H3、H4)氨基酸序列都非常相似, 如海胆组织H3的氨基酸序列与来自小牛胸腺的H3的氨基酸序列间只有一个氨基酸的差异, 小牛胸腺的H3的氨基酸序列与豌豆的H3也只有4个氨基酸不同。不同生物的H1序列变化
 技术资料
技术资料暂无技术资料 索取技术资料





![Cytokeratin 19 antibody [N1C1]](https://img1.dxycdn.com/2022/0328/640/9538429605449200453-14.jpg!wh200)
![CD43 antibody [MEM-59]](https://img1.dxycdn.com/2022/0328/074/6778967932740400453-14.jpg!wh200)

![HSP60 antibody [LK1]](https://img1.dxycdn.com/2022/0328/826/6089909931150700453-14.jpg!wh200)

